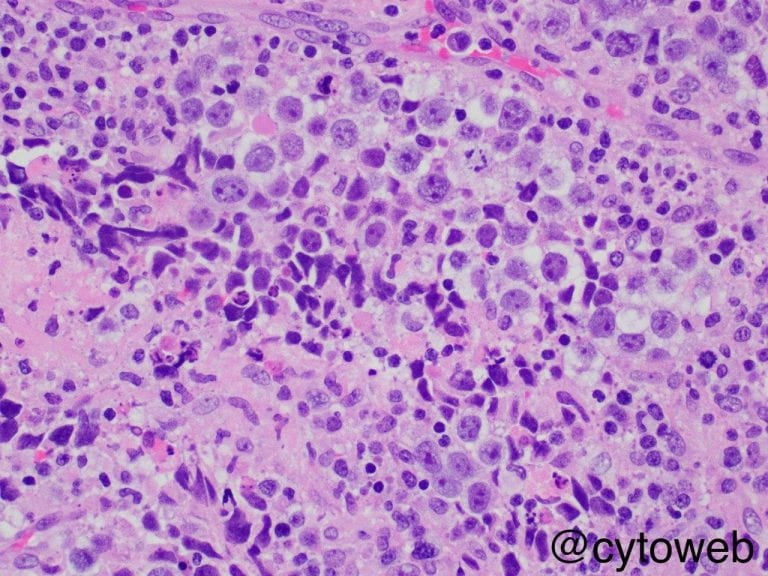

Thoracic case 1
A heavy chest mass
Clinical history: A 25-year-old man presented with chest discomfort, reduced effort tolerance and symptoms of vena cava obstruction. Imaging revealed a 15 cm anterior mediastinal mass. A frozen section was performed, and an imprint of the fresh specimen is shown.
Case writer: Dr Noel Chia